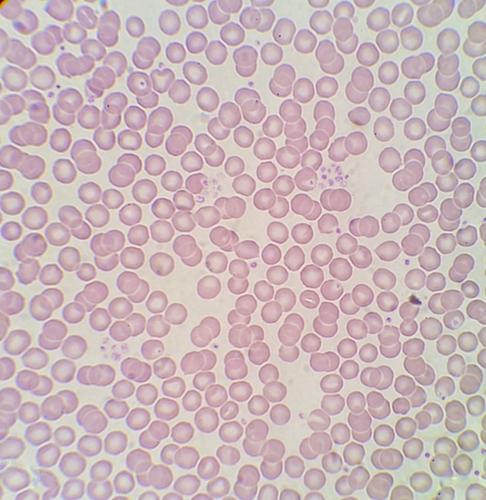

Blood 'master switch' may help end platelet shortages
IANS May 22, 2017
Researchers have identified a "master switch" that may one day help overcome the obstacles that have prevented doctors from producing platelets in large quantities outside the body.
The discovery may be the key to stopping shortages of platelets, vital blood-clotting cells that can represent the difference between life and death."The platelet supply is limited and the demand is growing," said one of the researchers Adam Goldfarb from the University of Virginia School of Medicine in the US."The quantities we can produce outside the body are very, very small, and the inability to scale up right now is a major roadblock. We think that our understanding of this pathway is actually a critical step toward fixing that problem," Goldfarb said.
The 'switch' discovered by Goldfarb's team controls whether the bone marrow produces cells called megakaryocytes of the type seen in adults or of the sort found in infants. This is important because the adult and infantile versions have very different specialties.Adult megakaryocytes are great at making platelets. Infantile megakaryocytes, on the other hand, are much smaller cells, and they concentrate on dividing to produce more megakaryocytes.The ability to toggle between the two could be a huge asset for doctors.Now, doctors cannot produce large quantities of platelets in the lab and instead must rely on platelet donations for patients.The new finding, reported in the Journal of Clinical Investigation, however, may help change that.
"It's thought that in our bodies every single megakaryocyte produces like a thousand platelets, and when you do it in culture (outside the body) it's like 10," Goldfarb said."We think the pathway we're studying enhances the efficiency of platelet release, and this pathway, we think, could be manipulated in both directions: to suppress the pathway to promote the growth (of megakaryocytes) and then to activate the pathway at some point to enhance the efficiency of platelet release," he added.
-
Exclusive Write-ups & Webinars by KOLs
-
Daily Quiz by specialty
-
Paid Market Research Surveys
-
Case discussions, News & Journals' summaries